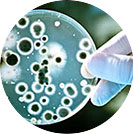

ПОНАД 32000 ОСІБ ВЖЕ ЗАХИСТИЛИ СВІЙ УРОЖАЙ
БІОДОБРИВО AGROPLANT ЕКСТРЕНА ДОПОМОГА ВАШОМУ ВРОЖАЮ
Agroplant - інноваційна розробка НДІ проблем меліорації України. За допомогою цього біодобрива можна отримати гарний врожай навіть на низькородючих ґрунтах і в складних кліматичних умовах. Застосувавши Agroplant на своїй ділянці, ви отримаєте дивовижні результати - врожай значно підвищиться, а вітаміни та мікроелементи, що містяться в ньому, допоможуть захистити рослину від хвороб і шкідників на весь сезон. За даними мінсільгоспу за 2021 рік за допомогою Agroplant в Україні вже врятовано близько 189 тисяч тонн врожаю овочів і фруктів.
-

Підходить для овочів, фруктів, ягід і квітів
-

Захищає рослини та розсаду від шкідників і хвороб
-

Повністю безпечне, не містить нітратів та інших неорганічних сполук
Секрет ефективності біодобрива полягає не тільки в унікальному складі, а й в особливому форм факторі - дрібнодисперсних гранулах. Гранули закладаються в лунки під час посадки для великих рослин, або рівномірно розсіюються по площі грядки для дрібних. Спочатку відбувається підживлення розсади або насіння для збільшення схожості (до 80%), далі рослина обплітаючи кожну гранулу своїм корінням, бере з неї саме ті елементи, які їй потрібні в даний момент, протягом усього сезону!
ЗАМОВИТИ ЗАРАЗ